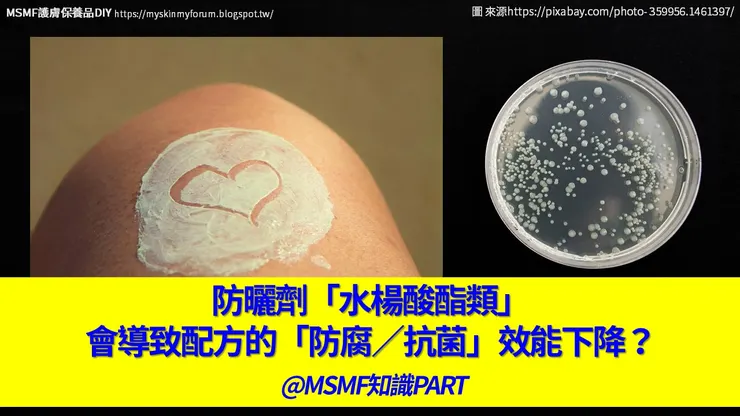
vocus｜新世代的創作平台

研究發現:相同配方,當添加「Octyl Salicylate(水楊酸辛酯)或Homosalate(甲基水楊醇)」等紫外線吸收劑後──原本對「綠膿桿菌(Pseudomonas aeruginosa)與洋蔥假單胞菌(Burkholderia cepacia)」的有效抗菌效能,反而失效...
因保養品本身的特性,通常「非一次性」用完,會被反覆沾取(人為微生物汙染),加上又往往「室溫」環境存放──所以,使保養品有非常高的機率,遭受「微生物污染/破壞而變質」的狀況。也更容易進一步衍生「皮膚健康危害」的風險。
因此,在肌膚保養品:配方中配置適當的「防腐」組合(系統)──是「必要之惡」!
然而「防腐劑」對皮膚細胞兒而言,畢竟也是種「刺激成分」──潛在造成肌膚「敏感/刺痛/泛紅」等不適症狀得凶手──所以,大家在確保配方「有效防腐(=通過「防腐挑戰性試驗(Antimicrobial Effectiveness Testing)」能力充足的同時;也會盡量壓抑/縮減防腐劑的添加量。
讓配方的「防腐效能」維持在一個「恰好足效、又不會引起刺激反應」的臨界範圍。
而處於臨界範圍的「防腐劑(們)」──若被配方中其它配伍成分影響,稍微壓抑了部分防腐劑的效能──延伸結果:可能就會大幅提升出現「微生物污染」的風險。
因此,了解「防腐劑 vs. 配伍成分 vs. 微生物」之間的潛在關聯性?有何影響?(e.g.增強or削弱-配方防腐效能)是配方師們不斷持續學習跟進的課題。
防曬劑「水楊酸酯類」vs. 配方「防腐挑戰性試驗」的抗菌效能影響?
近日Noa Ziklo等人研究《Salicylate UV-Filters in Sunscreen Formulations Compromise the Preservative System Efficacy against Pseudomonas aeruginosa and Burkholderia cepacia》指出:
- 3種保養品配方:SPF-30防曬、SPF-45防曬、與基本乳霜(O/W)──在「添加vs.不添加」有Octyl Salicylate(水楊酸辛酯)或Homosalate(甲基水楊醇)等紫外線吸收劑狀況下──同樣的0.5%防腐劑組合(其中含80% Phenoxyethanol, 5% Didecyldimethylammonium chloride, 10% Chlorophenesin, and 5% Caprylyl glycol.),對「防腐挑戰性試驗」結果的影響?
- 發現:原本能有效抑制「綠膿桿菌(P. aeruginosa)與洋蔥假單胞菌(B. cepacia)」的生長防腐劑組合──在配方添加「水楊酸酯類」紫外線吸收劑之後,反而失去對這2種細菌的抗菌能力。(參下圖)

研究人員認為:這是因為防曬劑「水楊酸酯類」被微生物酵素水解後,產生的「水楊酸」激活了與「秋水仙素(pyochelin)」相關的生化反應,幫助綠膿桿菌(P. aeruginosa)與洋蔥假單胞菌(B. cepacia),有效維持生存在這「防腐劑存在的惡劣環境」中,得以維持自身族群的生長。
MSMF觀點:
若依這篇研究,延伸來看──如果這類常見於防曬品中的「水楊酸酯類」紫外線吸收劑(成分),可能透過激活微生物的某些「生化代謝路徑」反應,進而使這些伺機性病原菌,出現「抗藥性(對防腐劑的抵抗力)」──那我們是不是應該針對這類防曬配方:
- 更「加重/強化」的其防腐劑組合(%)?──不過這樣做(e.g.加重防腐劑%、或改用更強效類型的防腐成分),會不會又衍伸出其它的問題,如提高皮膚發生「刺激/敏感現象」的機率?
- 或調整配伍組成,避免使用「水楊酸酯類」防曬劑?──然後等於重新開發新的「防曬配方」:重測SPF值、重抓使用膚感、重新觀察安定性/瓶器相容性測試......等,所有「開發作業(項目)」都得再跑一遍。
總而言之──都是需要再投入更多的成本(人力、資源&時間)去進行驗證!
所以說:成功配方=20%理論+80%實驗!
「配方」實際如何?
還是得乖乖打樣/配製出來──才能「實測」後,再大聲說。
*My Skin My Forum, MSMF 【護膚保養品diy交流】 FB粉絲頁 &Youtube頻道
*成功配方=20%理論+80%實驗!



















